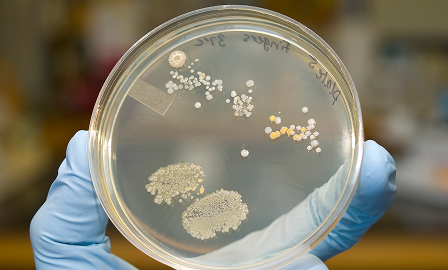

OVERVIEW
Industrial microbiology harnesses the power of microorganisms to drive innovation across sectors like pharmaceuticals, food production, environmental management, and bioenergy. By optimizing microbial processes, industries can create everything from antibiotics to sustainable bioplastics more efficiently and responsibly.
This field is not just about production, it is about precision and control. Understanding how microbes behave under different conditions allows companies to scale processes, maintain quality, and meet the growing demand for safe, sustainable products worldwide.

PROCESS

Production or Process Goal Established
Microorganisms are employed for applications such as fermentation, enzyme production, or bioremediation.
Strain Optimization and Cultivation
Microbes are cultured under optimized conditions to maximize yield, stability, or activity.

Scale-Up and Quality Assurance
Processes are scaled for commercial use with rigorous monitoring to ensure consistency, efficiency, and regulatory compliance.

